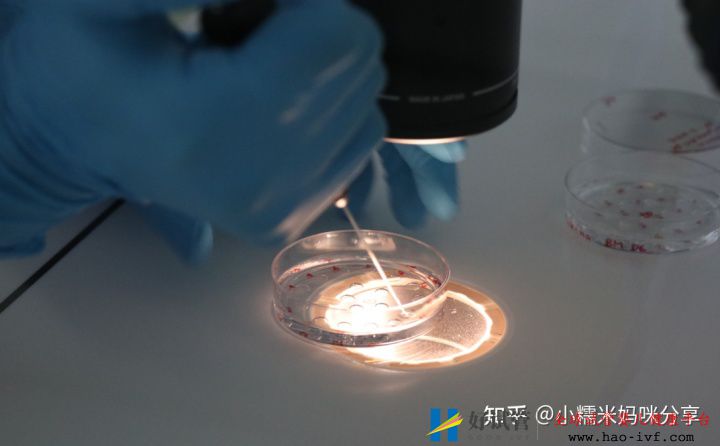
多囊姐妹做三代试管技术有多高成功率(图1)

多囊姐妹做三代试管技术有多高成功率
多囊可以做试管婴儿吗?
虽然多囊卵巢合征能通过试管婴儿助孕,但这并不是优先的选择。对于单纯的多囊卵巢综合征的患者,绝大多数是不需要进行辅助生育的,只要通过促排卵的方法就能怀孕。
对于少数通过促排卵的方法怀孕无果的患者,那么还可以通过腹腔镜下多囊卵巢你打孔术配合药物调理进行治疗,临床表明术后怀孕率还是很高的,所以建议多囊卵巢综合征的患者先尝试治疗自然怀孕,而不是首选去做试管婴儿。
多囊做试管婴儿成功率大吗?
我们都知道,试管婴儿是将J子和卵子取出后在体外结合成受精卵后再进行胚胎移植的过程,这就对患者的卵子质量有较高的要求,而多囊患者一般存在激素异常的情况,内分泌的紊乱会导致卵子发育异常、卵泡质量下降,从这一点上说可能会降低试管婴儿的妊娠率。因此,多囊患者做试管的成功率不是特别高,但仍能做成功。
试管的成功率是100%?
并不是100%,国内比较厉害的体外受精着床率,比如北三院,它的试管成功率也是才百分之五六十左右,欧美试管婴儿成功率更高一些,我国由于技术、专家方面的限制,各地医院试管婴儿技术发展参差不齐,没有统一的官方样本调查数据。

多囊卵巢在生活方面如何调理?
1、调整生活方式 :多囊卵巢综合征女性最常见临床表现是肥胖,因此多囊肥胖患者寻求妊娠的首要方法就是降低体重,增加受孕几率。
2、作息规律:作息不规律非常容易内分泌失调,有的女性经常熬夜加班加点,就会出现月经不调的症状,这是会影响到排卵的。
3、饮食方面调整:多囊的姐妹在饮食方面一定要注意,多补充高蛋白、营养元素比较高的食物。





